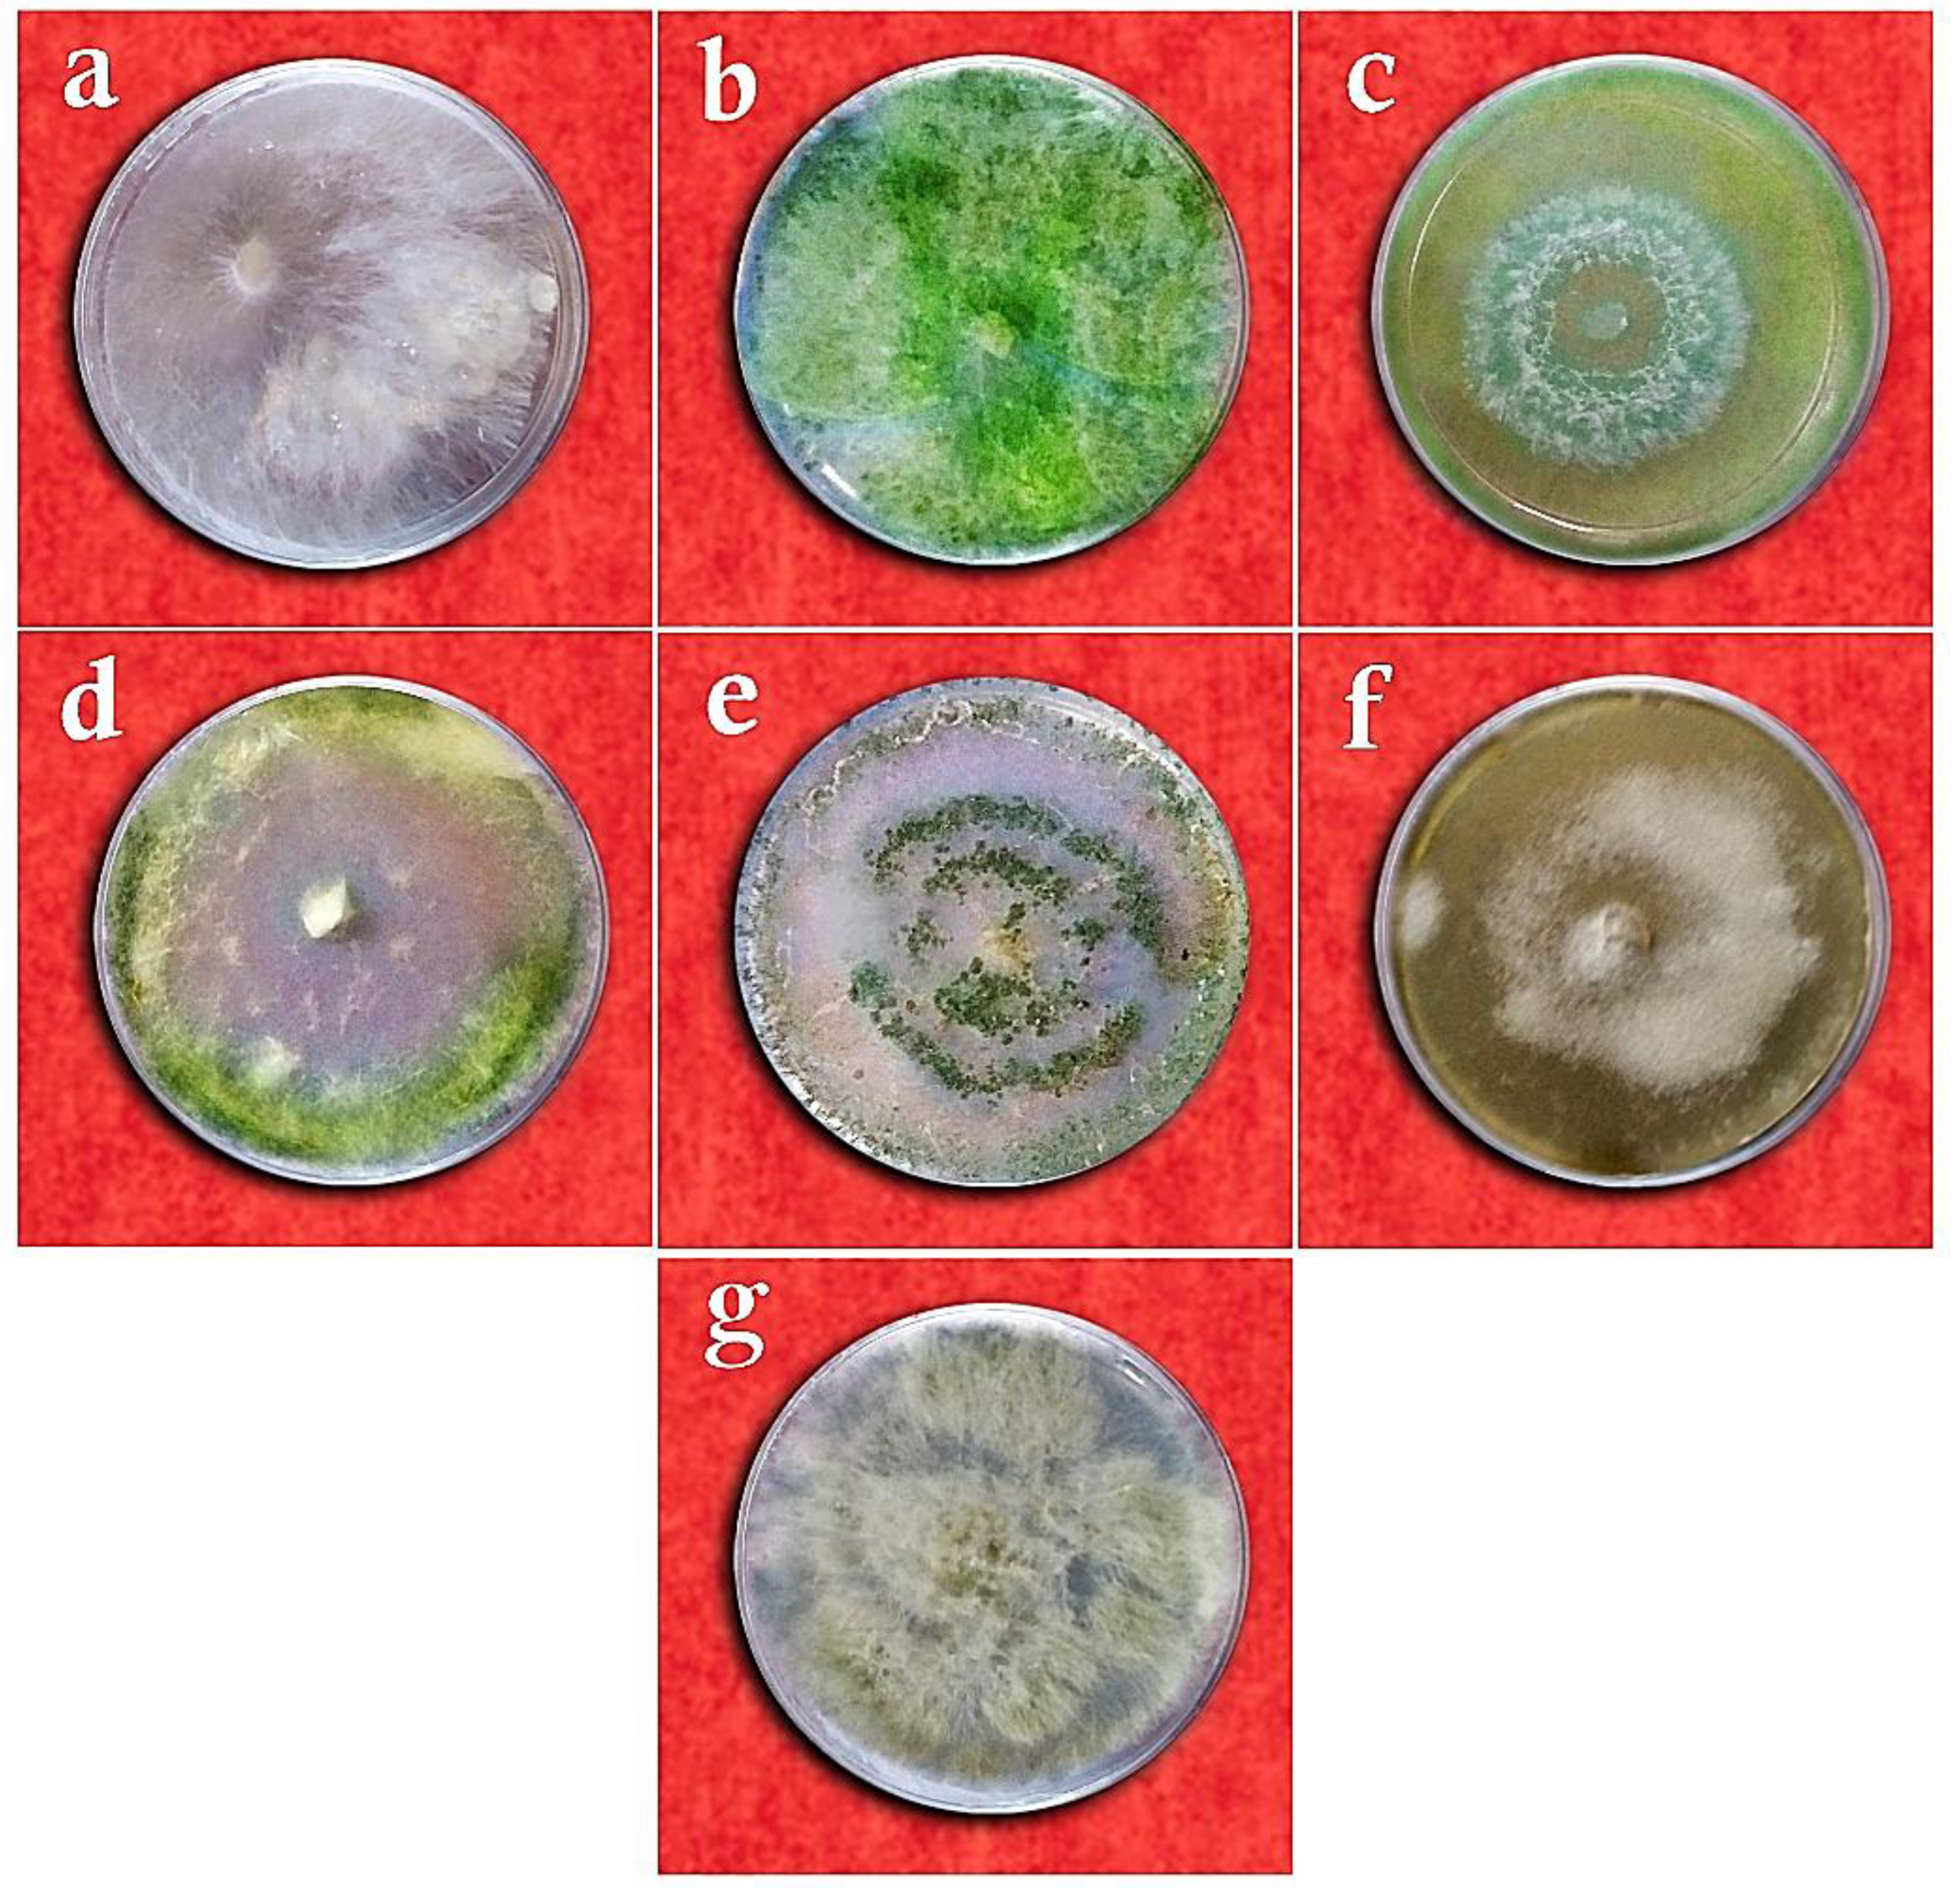
Cells 11 02643 g005
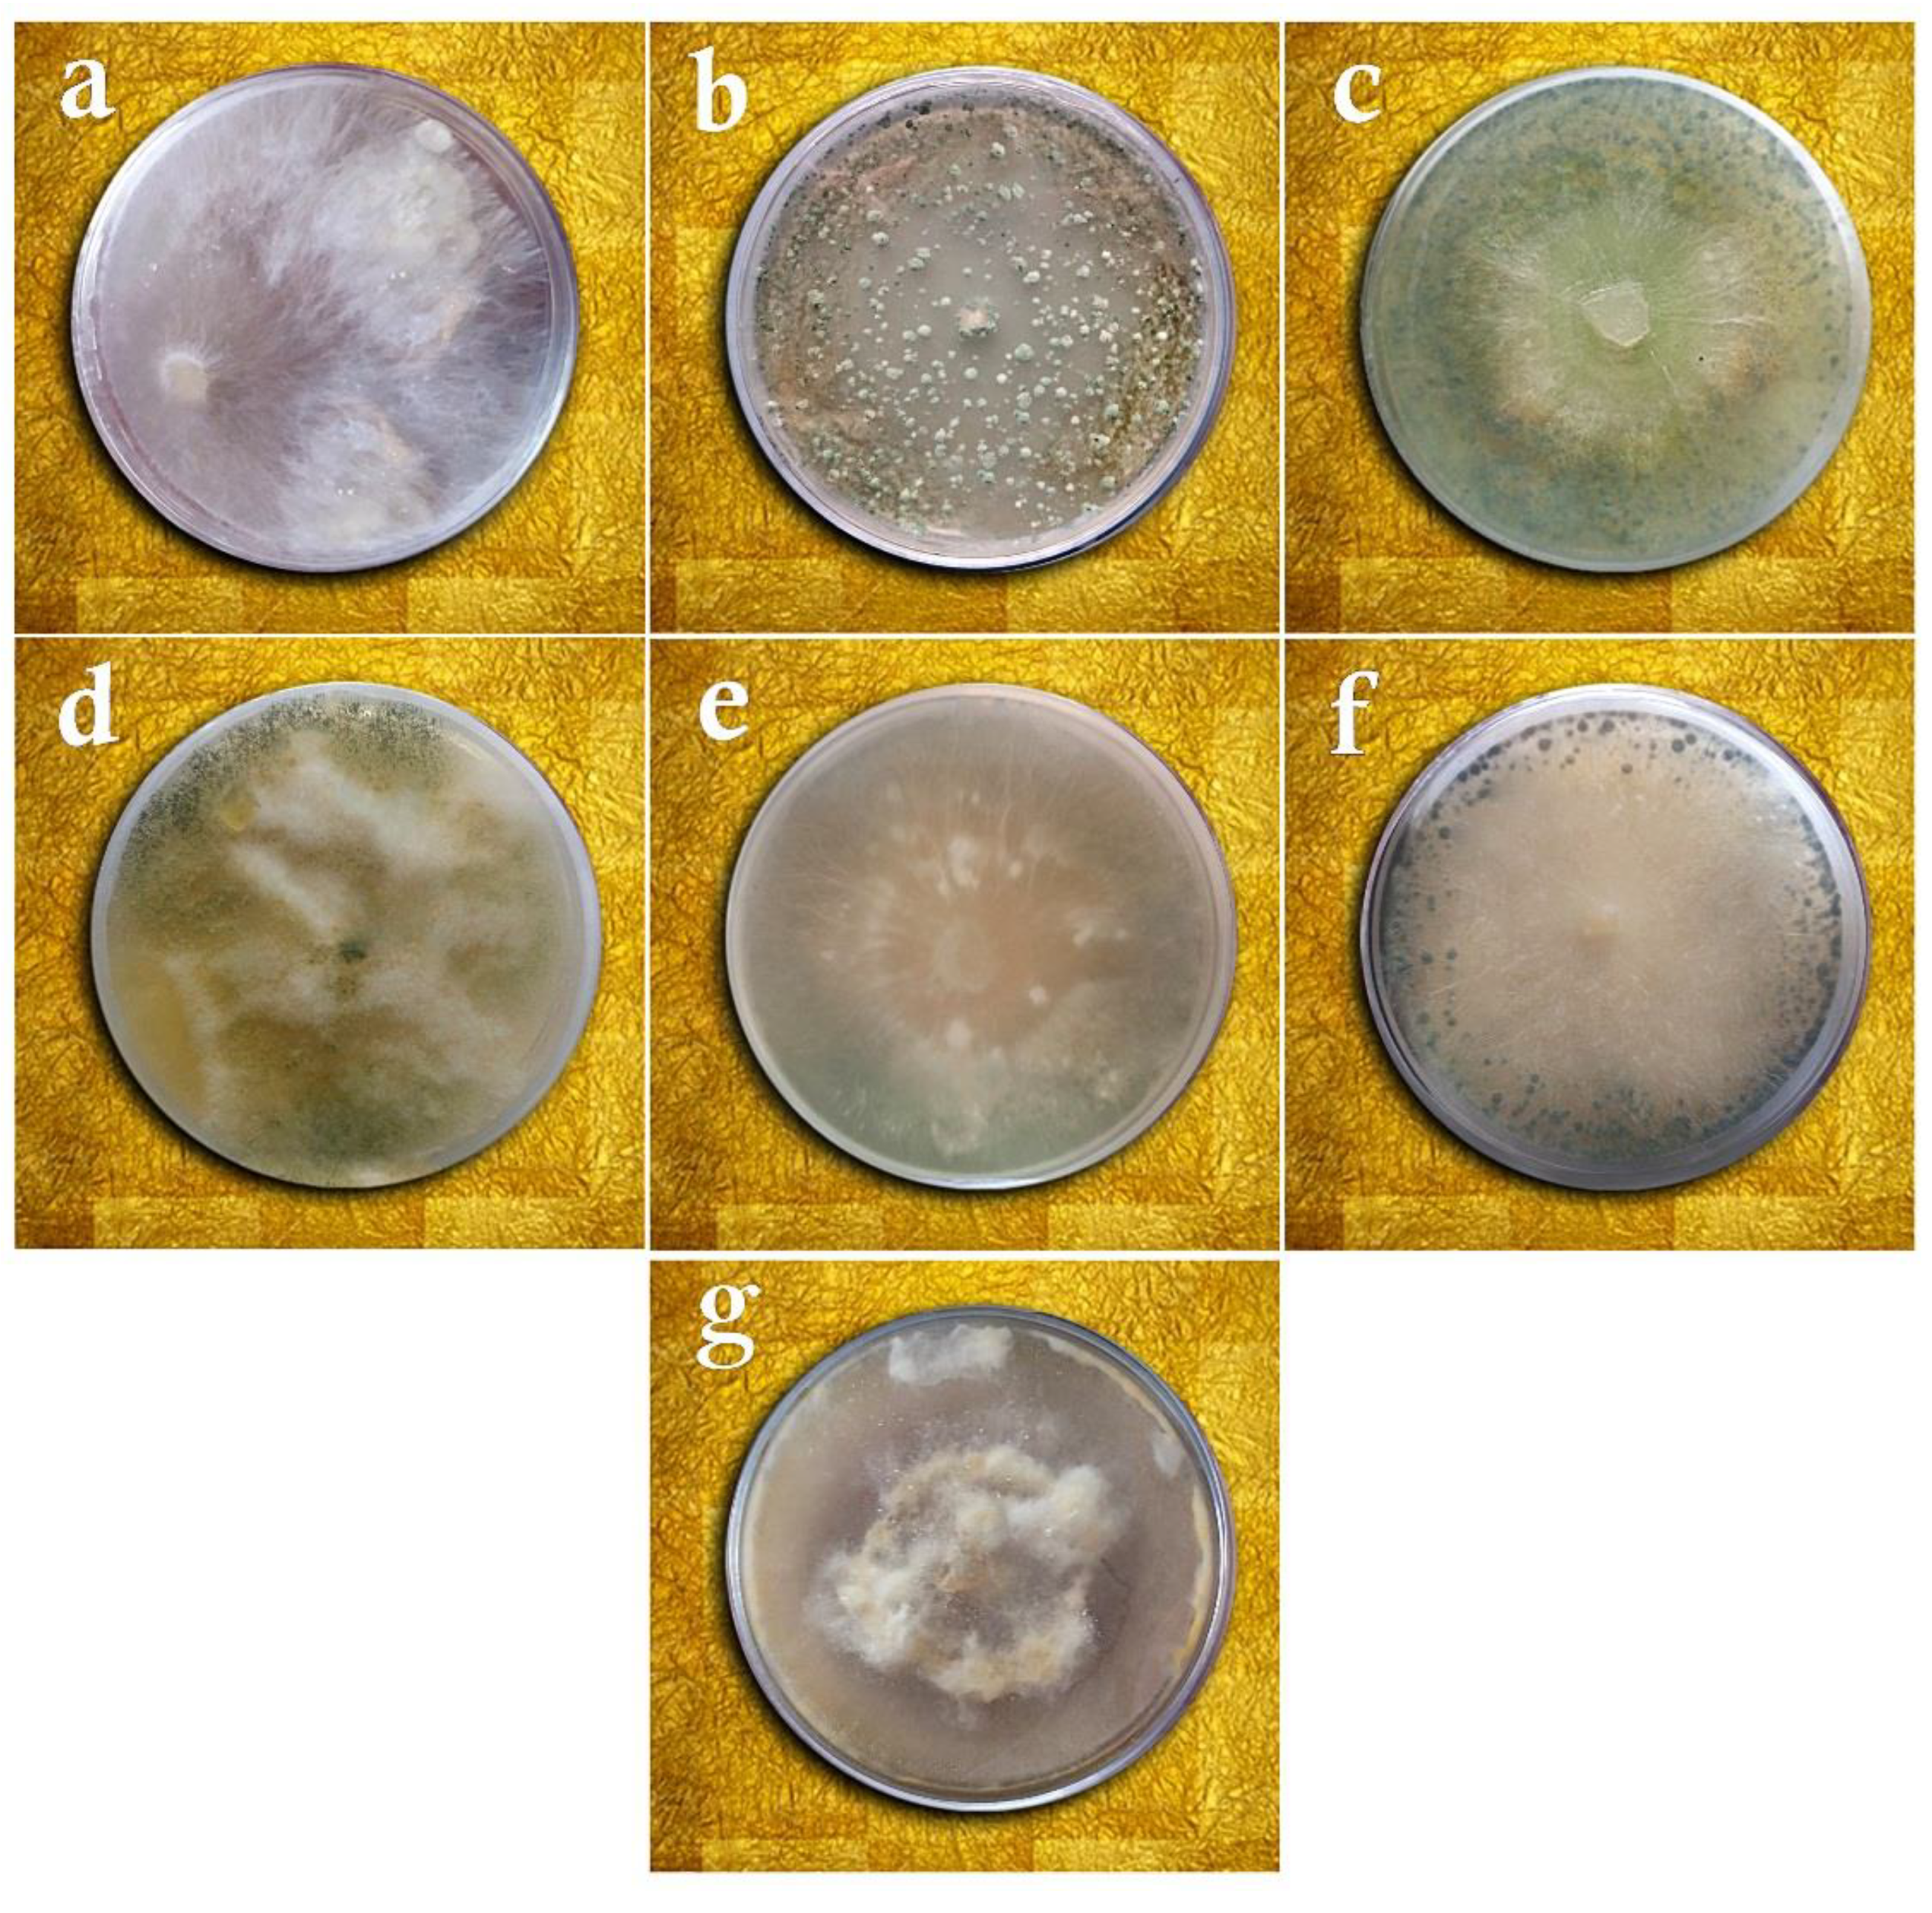
Cells 11 02643 g006

Endophytic Fungi as Potential Biocontrol Agents against Sclerotium rolfsii Sacc.—The Causal Agent of Peanut White Stem Rot Disease
Abstract
1. Introduction
2. Materials and Methods
2.1. Sampling, Isolation, Purification, and Identification of the Fungal Isolates
2.2. Genetic Analysis
2.3. In Vivo Pathogenicity Test
2.4. In Vitro Biocontrol Assay
2.4.1. Dual Culture Method
2.4.2. Assay of Volatile Metabolites Effect
2.4.3. Assay of Growth Inhibitory Effect of Non-Volatile Compounds (Culture Extract)
2.4.4. Hyperparasitism Test (Slide Culture)
2.5. Biocontrol Studies in the Greenhouse
2.6. Statistical Analysis
3. Results
3.1. Taxonomy of Fungal Isolates Based on Morphological and Molecular Traits
3.2. In Vitro Biocontrol Assays
3.3. Biocontrol Studies in Greenhouse Conditions
4. Discussion
5. Conclusions
Author Contributions
Funding
Institutional Review Board Statement
Informed Consent Statement
Data Availability Statement
Acknowledgments
Conflicts of Interest
References
- Agrios, G. Plant Pathology, 5th ed.; Elsevier Academic Press: Amsterdam, The Netherlands, 2005. [Google Scholar]
- Akgul, D.S.; Ozgonen, H.; Erkılıc, A. The effects of seed treatments with fungicides on stem rot caused by Sclerotium rolfsii Sacc., in peanut. Pak. J. Bot. 2011, 43, 2991–2996. [Google Scholar]
- Lehner, M.S.; Júnior, T.J.P.; Silva, R.A.; Vieira, R.F.; Carneiro, J.E.S.; Schnabel, G.; Mizubuti, E.S.G. Fungicide Sensitivity of Sclerotinia sclerotiorum: A Thorough Assessment Using Discriminatory Dose, EC50, High-Resolution Melting analysis, and Description of New Point Mutation Associated with Thiophanate-Methyl Resistance. Plant Dis. 2015, 99, 1537–1543. [Google Scholar] [CrossRef]
- McDonald, B.A.; Linde, C. Pathogen Population Genetics, Evolutionary Potential, and Durable Resistance. Annu. Rev. Phytopathol. 2002, 40, 349–379. [Google Scholar] [CrossRef]
- Fontana, D.C.; de Paula, S.; Torres, A.G.; de Souza, V.H.M.; Pascholati, S.F.; Schmidt, D.; Dourado Neto, D. Endophytic Fungi: Biological Control and Induced Resistance to Phytopathogens and Abiotic Stresses. Pathogens 2021, 10, 570. [Google Scholar] [CrossRef]
- Upadhyay, J.P.; Mukhyopadhayay, A.N. Biological control of Sclerotium rolfsii by Trichoderma harzianum in sugarbeet. Int. J. Pest Manag. 1986, 32, 215–220. [Google Scholar] [CrossRef]
- Dharmaputra, S. The Possibility of Controlling Sclerotium rolfsii on Soybean (Glycine Max) Using Trichoderma and Tebuconazole. BIOTROPIA-Southeast Asian J. Trop. Biol. 1994, 7, 18–29. [Google Scholar] [CrossRef]
- Radwan, M.B.; Fadel, A.M.; Mohammad, I.A.M. Biological control of Sclerotium rolfsii by using indigenous Trichoderma spp. isolates from Palestine. Hebron Univ. Res. J. 2006, 2, 27–47. [Google Scholar]
- Anahosur, K.H. Integrated management of potato Sclerotium wilt caused by Sclerotium rolfsii. Indian Phytopathol. 2001, 54, 158–168. [Google Scholar]
- Gancsan, S.; Ganesh Kuppusamy, R.; Sekar, R. Integrated management of stem rot disease (Sclerotium rolfsii) of groundnut (Arachis hypogaea L.) using Rhizobium and Trichoderma harzianum (ITCC-4572). Turkish. J. Agric. For. 2007, 3, 103–108. [Google Scholar]
- Islam, M.M.; Hossain, D.M.; Nonaka, M.; Harada, N. Biological control of tomato collar rot induced by Sclerotium rolfsii using Trichoderma species isolated in Bangladesh. Arch. Phytopathol. Plant Prot. 2016, 50, 109–116. [Google Scholar] [CrossRef]
- Bosah, O.; Igalek, C.A.; Omorusi, V.I. In vitro microbial control of pathogenic Sclerotium rolfsii. Int. J. Agric. Biol. 2010, 12, 474–476. [Google Scholar]
- Vikram, A.; Hamzehzarghani, H. Integrated management of Sclerotium rollfsii in groundnut (Arachis hypogaea L.) under pot culture conditions. Pest Technol. 2011, 5, 33–38. [Google Scholar]
- Bindu Madhavi, G.; Bhattiprolu, S.L. Integrated disease management of dry root rot of chilli incited by Sclerotium rolfsii Sacc. Int. J. Plant Animal Env. Sci. 2011, 1, 31–37. [Google Scholar]
- Darvin, G.; Kumari, V.P. Effect of biocontrol agents on radial growth of Sclerotium rolfsii in vitro. Int. J. Appl. Biol. Pharm. Technol. 2013, 4, 61–64. Available online: https://www.fortunejournals.com/ijabpt/pdf/24009-G.%20Darvin.pdf (accessed on 1 December 2013).
- Sabet, K.K.; Saber, M.M.; El-Naggar, M.A.-A.; El-Mougy, N.S.; El-Deeb, H.M.; El-Shahawy, I.E.-S. Using Commercial Compost as Control Measures against Cucumber Root-Rot Disease. J. Mycol. 2013, 2013, 1–13. [Google Scholar] [CrossRef]
- Basumatary, M.; Dutta, B.K.; Singha, D.M.; Das, N. Some in vitro observations on the biological control of Sclerotium rolfsii, a serious pathogen of various agricultural crop plants. J Agric. Vet. Sci. 2015, 8, 87–94. [Google Scholar] [CrossRef]
- Nawar, L.S. In vitro efficacy of some fungicides, bioagents and culture filtrates of selected saprophytic fungi against Sclerotium rolfsii. Life Sci. J. 2013, 10, 2222–2228. [Google Scholar]
- Liu, J.Y.; Hui, J.F.; Sun, M.Y.; Liu, X.S.; Lu, W.H.; Ma, C.H.; Zhang, Q.B. Effects of phosphorus application level, inoculation of AMF and Phosphorus Solubilizing Bacteria on Alfalfa Yield and phosphorus utilization efficiency. J. Agric. Eng. 2020, 36, 142–149. [Google Scholar] [CrossRef]
- Doley, K.; Dudhane, M.; Borde, M. Biocontrol of Sclerotium rolfsii in groundnut by using microbial inoculants. Not. Sci. Biol. 2017, 9, 124–130. [Google Scholar] [CrossRef][Green Version]
- Booth, C. Methods in Microbiology; Academic Press: London, UK, 1971. [Google Scholar]
- Mehri, Z.; Khodaparast, S.A.; Mosa Nejad, S. Genetic diversity in Sclerotium rolfsii population based on mycelial compatibility groups in Guilan province, Iran. Iran. J. Plant Pathol. 2013, 49, 317–324. [Google Scholar]
- Punja, Z.K.; Grogan, R.G. Basidiocarp induction, nuclear condition variability and heterokaryon incompatibility in Athelia (Sclerotium) rolfsii. Phytopathology 1983, 73, 1273–1278. [Google Scholar] [CrossRef]
- Gams, W.; Bissett, J. Morphology and Identification of Trichoderma. In Trichoderma and Gliocladium. Taxonomy and Genetics; Kubicek, C.P., Harman, G.E., Eds.; Taylor and Francis Ltd.: Abingdon, UK, 1998; pp. 3–34. [Google Scholar]
- Pitt, J.I.; Hocking, A.D. Fungi and Food Spoilage; Springer: New York, NY, USA, 2009. [Google Scholar]
- Amaike, S.; Keller, N.P. Aspergillus flavus. Annu. Rev. Phytopathol. 2011, 49, 107–133. [Google Scholar] [CrossRef]
- White, T.J.; Bruns, T.; Lee, S.; Taylor, J. Amplification and direct sequencing of fungal ribosomal RNA genes for phylogenetics. In PCR Protocols: A Guide to Methods and Applications; Innis, M.A., Gelfand, D.H., Sninsky, J.J., White, T.J., Eds.; Academic Press: New York, NY, USA, 1990; pp. 315–322. [Google Scholar]
- Kõressaar, T.; Lepamets, M.; Kaplinski, L.; Raime, K.; Andreson, R.; Remm, M. Primer3_masker: Integrating masking of template sequence with primer design software. Bioinformatics 2018, 34, 1937–1938. [Google Scholar] [CrossRef] [PubMed]
- The National Center for Biotechnology Information. Available online: http://www.ncbi.nlm.nih.gov (accessed on 2 August 2022).
- Sennoi, R.; Jogloy, S.; Saksirriat, W.; Kesmala, T.; Singkham, N.; Patanothai, A. Levels of Sclerotium rolfsii inoculums influence identification of resistant genotypes in Jerusalem artichoke. Afr. J. Microbiol. Res. 2012, 6, 6755–6760. [Google Scholar] [CrossRef]
- Singelton, L.L.; Mihail, J.D.; Rush, C. Methods for Research on Soil-Borne Phytopathogenic Fungi; American Phytopathological Society Press: St. Paul, MN, USA, 1992; p. 264. [Google Scholar]
- Yaqub, F.; Shahzad, S. Pathogenicity of Sclerotium rolfsii on different crops and effect of inoculums density on colonization of mungbea and sunflower roots. Pak. J. Bot. 2005, 37, 175–180. [Google Scholar]
- Sivakumar, D.; Wilson Wijeratnam, R.S.; Wijesundera, R.L.C.; Marikar, F.M.T.; Abeyesekere, M. Antagonistic effect of Trichoderma harzianum on postharvest pathogens of rambutan (Nephelium lappaceum). Phytoparasitica 2000, 28, 240–247. [Google Scholar] [CrossRef]
- Dennis, C.; Webster, J. Antagonistic properties of species-groups of Trichoderma: II. Production of volatile antibiotics. Trans. Br. Mycol. Soc. 1971, 57, 41–48. [Google Scholar] [CrossRef]
- Burgess, D.R.; Hepworth, G. Biocontrol of sclerotinia stem rot (Sclerotinia minor) in sunflower by seed treatment with Gliocladium virens. Plant Pathol. 1996, 45, 583–592. [Google Scholar] [CrossRef]
- Dennis, C.; Webster, J. Antagonistic properties of species-groups of Trichoderma: I. Production of non-volatile antibiotics. Trans. Br. Mycol. Soc. 1971, 57, 25–39. [Google Scholar] [CrossRef]
- Horsfall, J.G.; Barratt, R.W. An improved grading system for measuring plant disease. Phytopathology 1945, 35, 655. [Google Scholar]
- Le, C.N.; Kruijt, M.; Raaijmakers, J.M. Involvement of phenazines and lipopeptides in interactions between Pseudomonas species and Sclerotium rolfsii, causal agent of stem rot disease on groundnut. J. Appl. Microbiol. 2012, 112, 390–403. [Google Scholar] [CrossRef]
- Bertrand, P.F.; Gottwald, T.R. Evaluation of fungicides for pecan disease control. In Methods for Evaluating Pesticides for Control of Plant Pathogens; Hickey, K.D., Ed.; Oxford and IHB Publishing: Shapur, Delhi, 1997; pp. 179–181. [Google Scholar]
- Cardoso, J.E.; Santos, A.A.; Rossetti, A.G.; Vidal, J.C. Relationship between incidence and severity of cashew gummosis in semiarid north-eastern Brazil. Plant Pathol. 2004, 53, 363–367. [Google Scholar] [CrossRef]
- Akram, A.; Shaheen, I.; Akhund, S.; Nayyar, B.G.; Seerat, W. In vitro antifungal activity of Pongamia pinnata against collar rot pathogen (Sclerotium rolfsii) of Chickpea. Pure Appl. Biol. 2016, 5, 520–528. [Google Scholar] [CrossRef]
- Prasad, G.; Dwivedi, S.K. Efficacy of some bioagensts Sclerotium rolfsii sacc. Causing root rot Zea mays L. crop. Eur. J. Biomed. Pharm. Sci. 2017, 4, 478–481. [Google Scholar]
- Hung, R.; Lee, S.; Bennett, J.W. Fungal volatile organic compounds and their role in ecosystems. Appl. Microbiol. Biotechnol. 2015, 99, 3395–3405. [Google Scholar] [CrossRef]
- Inamdar, A.A.; Morath, S.; Bennett, J.W. Fungal Volatile Organic Compounds: More Than Just a Funky Smell? Annu. Rev. Microbiol. 2020, 74, 101–116. [Google Scholar] [CrossRef]
- Guo, Y.; Jud, W.; Weikl, F.; Ghirardo, A.; Junker, R.R.; Polle, A.; Benz, J.P.; Pritsch, K.; Schnitzler, J.-P.; Rosenkranz, M. Volatile organic compound patterns predict fungal trophic mode and lifestyle. Commun. Biol. 2021, 4, 673. [Google Scholar] [CrossRef]
- Rekha, D.; Patil, M.B.; Shridhar Shetty, P.; Swamy, K.M.; Gamanagatti, R.B. In vitro screening of native Trichoderma isolates against Sclerotium rolfsii causing collar rot of groundnut. Int. J. Sci. Nat. 2012, 3, 117–120. [Google Scholar]
- Samavat, S.; Heydari, A.; Zamanizadeh, H.R.; Rezaee, S.; Alizadehaliabadi, A. Comparison between Pseudomonas aureofaciens (chlororaphis) and P. fluorescens in biological control of cotton seedling damping-off disease. J. Plant Prot. Res. 2014, 54, 115–121. [Google Scholar] [CrossRef]
- Kakvan, N.; Heydari, A.; Zamanizadeh, H.R.; Rezaee, S.; Naraghi, L. Development of new bioformulations using Trichoderma and Talaromyces fungal antagonists for biological control of sugar beet damping-off disease. Crop Prot. 2013, 53, 80–88. [Google Scholar] [CrossRef]
- Vinale, F.; Sivasithamparam, K.; Ghisalberti, E.L.; Marra, R.; Woo, S.L.; Lorito, M. Trichoderma–plant–pathogen interactions. Soil Biol. Biochem. 2008, 40, 1–10. [Google Scholar] [CrossRef]
- Mirhosseini Moghadam, S.A.; Izadyar, M.; Rouhani, H. Antagonistic effect of Trichoderma and Gliocladium species on Sclerotium rolfsii, the causal agent of peanut stem rot. In Proceedings of the 13th Iranian Plant Protection Congress, Karaj, Iran, 23–27 August 1998; p. 404. [Google Scholar]
- Shakeel, Q.; Lyu, A.; Zhang, J.; Wu, M.; Li, G.; Hsiang, T.; Yang, L. Biocontrol of Aspergillus flavus on Peanut Kernels Using Streptomyces yanglinensis 3–10. Front. Microbiol. 2018, 9, 1049. [Google Scholar] [CrossRef]
- Bennett, A.J.; Whipps, J.M. Dual application of beneficial microorganisms to seed during drum priming. Appl. Soil Ecol. 2008, 38, 83–89. [Google Scholar] [CrossRef]
- Latunde-Dada, A.O. Biological control of southern blight disease of tomato caused by Sclerotium rolfsii with simplified mycelial formulations of Trichoderma koningii. Plant Pathol. 2007, 42, 522–529. [Google Scholar] [CrossRef]
- Parera, C.A.; Cantliffe, D.J. Improved Germination and Modified Imbibition of shrunken-2 Sweet Corn by Seed Disinfection and Solid Matrix Priming. J. Am. Soc. Hortic. Sci. 1991, 116, 942–945. [Google Scholar] [CrossRef]
- Naraghi, M.R.; Heidari, A.; Zamanizadeh, H.; Rezaei, S. Evaluation of biological control of Sclerotium cepivorum using Trichoderma and Talaromyces isolates in laboratory, greenhouse and field. In Proceedings of the 22th Iranian Plant Protection Congress, Karai, Iran, 27–30 August 2016; p. 404. [Google Scholar]
- Tang, Z.; Rao, L.; Peng, G.; Zhou, M.; Shi, G.; Liang, Y. Effects of endophytic fungus and its elicitors on cell status and alkaloid synthesis in cell suspension cultures of Catharanthus roseus. J. Med. Plant. Res. 2011, 5, 2192–2200. [Google Scholar] [CrossRef]
- Wink, M. Functions and Biotechnology of Plant Secondary Metabolites. In Annual Plant Reviews Volume 39, 2nd ed.; Blackwell Publishing Ltd.: Hoboken, NJ, USA, 2010. [Google Scholar]
- Dong, H.Z.; Cohen, Y. Extracts of killed Penicillium chrysogenum induce resistance against Fusarium wilt of melon. Phytoparasitica 2001, 29, 421–430. [Google Scholar] [CrossRef]
- Dong, H.Z.; Cohen, Y. Dry mycelium of Penicillium chrysogenum induces resistance against verticillium wilt and enhances growth of cotton plants. Phytoparasitica 2002, 30, 147–157. [Google Scholar] [CrossRef]
- Zargar, D.; Amini, J.; Abdollahzadeh, J. Biocontrol potential of endophytic Penicillium spp. against straw-berry anthracnose. Biol. Control Pest. Plant Dis. 2018, 8, 47–58. [Google Scholar] [CrossRef]
- Bhuiyan, S.A.; Ryley, M.J.; Galea, V.J.; Tay, D. Evaluation of potential biocontrol agents against Claviceps africana in vitro and in vivo. Plant Pathol. 2003, 52, 60–67. [Google Scholar] [CrossRef]

| Name | Sequence (5′→3′) | TM | GC% | Mer |
|---|---|---|---|---|
| 18s rDNA-F | CACCAGACTTGCCCTCCA | 58.24 | 61.1 | 18 |
| 18s rDNA-R | AACCTGGTTGATCCTGCCAG | 59.35 | 55 | 20 |
| Treatments | Dual Culture (%) | Volatile Metabolites (%) | Non-Volatile Metabolites (%) |
|---|---|---|---|
| Aspergillus flavus | 45.50 ± 0.01 c | 73.50 ± 0.08 b | 0.00 ± 0.00 c |
| Penicillium decaturense | 0.00 ± 0.00 d | 0.00 ± 0.00 d | 0.00 ± 0.00 c |
| Penicillium rubens (MN395854.1) | 65.15 ± 0.02 b | 84.30 ± 0.01 a | 90.20 ± 0.10 b |
| Penicillium rubens (MN395851.1) | 0.00 ± 0.00 d | 7.03 ± 0.00 c | 0.00 ± 0.00 c |
| Trichoderma virens | 90.98 ± 0.15 a | 0.00 ± 0.00 d | 0.00 ± 0.00 c |
| Trichoderma viride | 66.89 ± 0.11 b | 0.00 ± 0.00 d | 91.80 ± 0.01 a |
| Treatment | Disease Rating ± SE | Reduced Severity of Disease (%) ± SE | Disease Incidence (%) ± SE |
|---|---|---|---|
| Aspergillus flavus +S.rolfsii | 2.90 ± 0.09 cd | 42.00 ± 0.01 b | 32.00 ± 0.09 d |
| Penicillium decaturense +S.rolfsii | 3.30 ± 0.44 bc | 32.00 ± 0.07 c | 38.00 ± 0.02 cd |
| Penicillium rubens (MN395851.1) + S. rolfsii | 3.40 ± 0.50 bc | 34.00 ± 0.10 c | 44.00 ± 0.12 c |
| Penicillium rubens (MN395854.1) + S. rolfsii | 3.06 ± 0.38 c | 38.00 ± 0.10 bc | 50.00 ± 0.15 b |
| Trichoderma virens +S.rolfsii | 3.60 ± 0.44 b | 28.00 ± 0.08 d | 52.00 ± 0.14 b |
| Trichoderma viride +S.rolfsii | 2.80 ± 0.44 d | 44.00 ± 0.06 b | 31.00 ± 0.04 d |
| Antagonistic fungi (only) | 0.00 ± 0.00 e | 100.00 ± 0.00 a | 0.00 ± 0.00 e |
| Distilled water (negative control) | 0.00 ± 0.00 e | 100.00 ± 0.00 a | 0.00 ± 0.00 e |
| Scierotium rolfsii (positive control) | 5.00 ± 0.01 a | 00.00± 0.00 e | 100.00 ± 0.00 a |
| Treatments | Height with Root (cm) ± SE | Fresh Weight with Root (g) ± SE | Dry Weight with Root (g) ± SE |
|---|---|---|---|
| Aspergillus flavus +S.rolfsii | 64.33 ± 1.76 ab | 14.17 ± 1.43 b | 2.19 ± 0.03 b |
| Aspergillus flavus (only) | 60.33 ± 0.33 b | 10.24 ± 0.76 bc | 1.21 ± 0.08 cd |
| Penicillium decaturense +S.rolfsii | 63.33 ± 0.67 ab | 11.30 ± 1.11 bc | 3.33 ± 0.73 a |
| Penicillium decaturense (only) | 60.33 ± 0.33 b | 6.52 ± 2.22 cd | 2.23 ± 0.34 b |
| Penicillium rubens (MN395851.1) + S. rolfsii | 63.33 ± 1.45 ab | 7.15 ± 2.21 c | 2.03 ± 0.49 bc |
| Penicillium rubens (MN395851.1) (only) | 60.67 ± 0.67 b | 6.05 ± 1.74 cd | 1.67 ± 0.37 c |
| Penicillium rubens (MN395854.1) + S. rolfsii | 67.00 ± 0.14 a | 6.46 ± 1.21 cd | 2.33 ± 0.23 b |
| Penicillium rubens (MN395854.1) (only) | 61.00 ± 1.00 b | 5.57 ± 0.88 d | 1.48 ± 0.18 c |
| Trichoderma virens +S.rolfsii | 60.33 ± 0.33 b | 4.52 ± 0.43 e | 1.82 ± 0.46 c |
| Trichoderma virens (only) | 60.00 ± 0.00 b | 2.76 ± 1.09 f | 1.16 ± 0.01 cd |
| Trichoderma viride +S.rolfsii | 68.00 ± 1.11 a | 17.26 ± 0.26 a | 1.88 ± 0.21 c |
| Trichoderma viride (only) | 65.33 ± 1.45 ab | 12.00 ± 0.00 bc | 1.62 ± 0.26 c |
| Distilled Water (negative control) | 60.03 ± 0.77 b | 6.06 ± 0.77 cd | 1.35 ± 0.17 cd |
| Sclerotium rolfsii (positive control) | 33.55 ± 0.36 c | 2.18 ± 0.13 f | 1.00 ± 0.11 d |
Publisher’s Note: MDPI stays neutral with regard to jurisdictional claims in published maps and institutional affiliations. |
© 2022 by the authors. Licensee MDPI, Basel, Switzerland. This article is an open access article distributed under the terms and conditions of the Creative Commons Attribution (CC BY) license (https://creativecommons.org/licenses/by/4.0/).
Share and Cite
Safari Motlagh, M.R.; Farokhzad, M.; Kaviani, B.; Kulus, D. Endophytic Fungi as Potential Biocontrol Agents against Sclerotium rolfsii Sacc.—The Causal Agent of Peanut White Stem Rot Disease. Cells 2022, 11, 2643. https://doi.org/10.3390/cells11172643
Safari Motlagh MR, Farokhzad M, Kaviani B, Kulus D. Endophytic Fungi as Potential Biocontrol Agents against Sclerotium rolfsii Sacc.—The Causal Agent of Peanut White Stem Rot Disease. Cells. 2022; 11(17):2643. https://doi.org/10.3390/cells11172643
Chicago/Turabian StyleSafari Motlagh, Mohammad Reza, Maryam Farokhzad, Behzad Kaviani, and Dariusz Kulus. 2022. "Endophytic Fungi as Potential Biocontrol Agents against Sclerotium rolfsii Sacc.—The Causal Agent of Peanut White Stem Rot Disease" Cells 11, no. 17: 2643. https://doi.org/10.3390/cells11172643
APA StyleSafari Motlagh, M. R., Farokhzad, M., Kaviani, B., & Kulus, D. (2022). Endophytic Fungi as Potential Biocontrol Agents against Sclerotium rolfsii Sacc.—The Causal Agent of Peanut White Stem Rot Disease. Cells, 11(17), 2643. https://doi.org/10.3390/cells11172643

